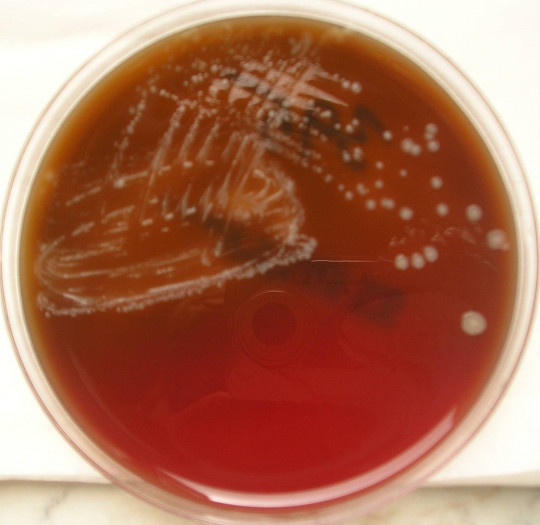
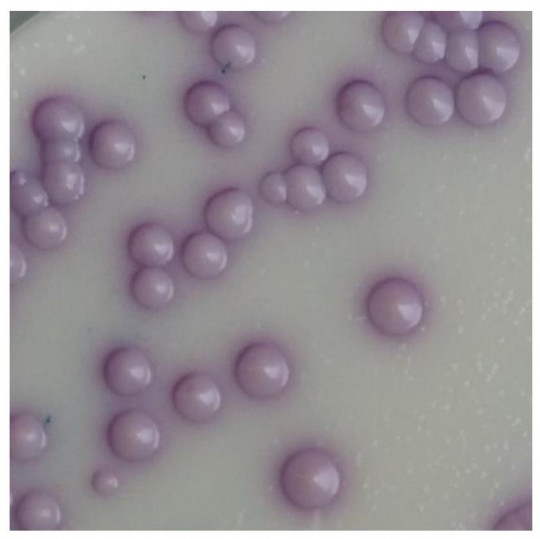
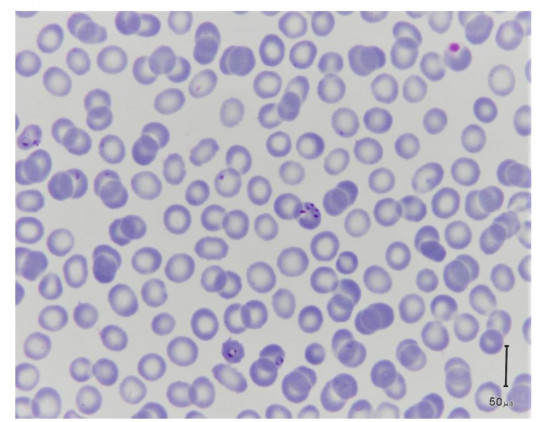

2.1
Mechanismy přenosu a šíření nákaz
Žádná nákaza nevznikne sama od sebe, ale její vývoj má své zákonitosti. V procesu vzniku a šíření nákazy se uplatňují tři nutné podmínky:
- její zdroj
- cesta a mechanismy přenosu
- další vnímavý jedinec
Chybí-li jeden z těchto faktorů (kvalitativně nebo kvantitativně), infekční onemocnění se nemůže šířit.
+

Obr. 4. Přenos infekce: zdroj, cesta, vnímavý jedinec
Možných zdrojů nákazy pro člověka může být několik. V první řadě to je infikovaný člověk. Dalším zdrojem může být zvíře, v tomto případě nazýváme vzniklé onemocnění jako zoonózou, resp. antropozoonózou. Zdrojem nákazy pro člověka mohou být i přenašeči onemocnění (vektory) nebo různé živočišné rezervoáry původců onemocnění. Všechny výše jmenované zdroje mohou kontaminovat vnější prostředí, které se pak také stává možným zdrojem nákazy.
Infikovaný člověk nemusí být manifestně nemocný, ale může se jednat o nosiče bez zjevných klinických projevů onemocnění. V tomto případě jsou infikované osoby tzv. bezpříznakoví nosiči. Totéž platí pro zvířata, vektory i rezervoáry. Osoby (zvířata) se zjevnou nákazou jsou snáze rozpoznatelné, při jejich zodpovědném jednání jsou pro šíření nemocí méně nebezpečné. Složitější, nebezpečnější a méně kontrolovatelná je situace u bezpříznakových nosičů, kteří o svém onemocnění nemusí vědět. Mohou tak vylučovat a šířit infekční agens při inaparentním průběhu onemocnění (latentním i chronickém), v jeho inkubační době nebo v rekonvalescentním období, které je ovšem při „bezpříznakovosti“ těžko časově identifikovatelné.
+

Obr. 5. Manifestnost onemocnění
Prostředí, jako zdroj nákazy pro člověka, musí být kontaminováno některou z níže jmenovaných kategorií organismů. Infikuje-li se člověk přímo od nemocného jedince (nebo nosiče), jedná se o přenos přímý, infikuje-li se prostřednictvím nějakého vehikula, jedná se o přenos nepřímý.
2.1.1
Původci nákaz a jejich vlastnosti
- Bakterie – do této skupiny patří celá řada prokaryotických jednobuněčných organismů, původců širokého spektra různých onemocnění po celém světě.
+
Obr. 6. Clostridium perfringens na kultivační půdě
+

Obr. 7. Clostridium perfringens mikroskopický preparát barvený dle Grama
- Viry – široká skupina nebuněčných organismů, které ke své reprodukci striktně vyžadují hostitelskou buňku. V našich podmínkách jsou společně s bakteriemi nejčastějšími a nejzávažnějšími původci infekčních onemocnění.
- Patogenní houby – patří sem původci kosmopolitně rozšířených povrchových mykóz, ale i systémových onemocnění, hlavně u imunosuprimovaných jedinců.
+
Obr. 8. Kvasinky na kultivační půdě chromogenní agar
+

Obr. 9. Kvasinky mikroskopický preparát barvený dle Grama
- Metazoa – mnohobuněčné parazitární organismy ze skupiny členovců a červů. Řada z nich působí infekce kosmopolitně (zákožka svrabová, škrkavka), někteří jsou vázáni na specifické klimatické podmínky (měchovci, krevničky), někteří hrají důležitou roli jako vektory onemocnění (specifické druhy komárů, veš šatní, klíšťata, štěnice).
+

Obr. 10. Tasemnice bezbranná (Taenia saginata) ve střevě člověka
- Protozoa – zástupci jednobuněčných parazitických organismů, kteří jsou v celosvětovém měřítku původci řady závažných onemocnění (plasmodia – původci malárie, leishmanie – původci leishmanióz, trypanosomy – původci spavé a Chagasovy nemoci, toxoplasma – původce toxoplasmózy a další).
+
Obr. 11. Původce tropické malárie – Plasmodium falciparum. Infikované erytrocyty
- Priony – jedná se pouze o infekční proteiny, které jsou původci tzv. pomalých infekcí (u člověka např. Creutzfeldt-Jakobova choroba).
Význam jednotlivých původců a jejich vlivu na zdraví člověka může být různý, je často závislý na oblasti výskytu, kde hrají často zásadní roli klimatické podmínky – (tropy, subtropy, mírný klimatický pás). Velký vliv na výskyt infekčních onemocnění má hygienická úroveň populace, chování jednotlivce a v neposlední řadě i příslušnost k určité etnické skupině.
Velkou roli ve významu jednotlivých infekcí hraje i časové období. Onemocnění, která v minulosti byla „metlou lidstva“, dnes mohou sehrávat jen podružnou roli (např. mor). Naopak se mohou objevovat nové hrozby, o kterých jsme dříve nevěděli nebo jsme neznali všechny souvislosti vzniku onemocnění. To ale neznamená, že do té doby onemocnění neexistovala (např. objev viru HIV v 80. létech minulého století, identifikace původců a způsobu přenosu lymské boreliózy atd.).
Velký vliv na vznik a průběh nákazy mají také individuální (druhové) vlastnosti původců a momentální dispozice (indispozice) potencionálního hostitele. Musíme si uvědomit, že vznik onemocnění (objevení klinických příznaků) není při ataku hostitele infekčním činitelem samozřejmostí. Patogenní organismus musí mít minimálně mechanismy na to, aby překonal funkční imunitní systém potencionálního hostitele.
2.1.1.1
Vlastnosti původce
Definice
Patogenita – schopnost konkrétního druhu vyvolat určitý patologický stav, vlastnost kvalitativní.
Virulence – vyjadřuje míru (stupeň patogenity jednotlivých kmenů (sérotypů) infekčních agens.
Toxicita – schopnost agens poškozovat hostitelský organismus produkcí endo nebo exotoxinů, ale i poškození vlastní imunitní reakcí hostitele, která byla původně namířena proti cizorodému agens.
Invazivita – schopnost agens pronikat do tkání a množit se v nich.
Vedle individuálních vlastností původců onemocnění jsou k vzniku nákazy u dalšího jedince důležité i další faktory.
Značnou roli hraje infekční dávka (počet mikroorganismů nutných k vyvolání infekce). Velikost infekční dávky je u různých původců rozdílná. U některých stačí několik málo jedinců, u druhých je nutná ataka mnoha tisíci jedinci. Např.:
- TBC, bacilární úplavice – několik jedinců až několik desítek bakterií
- Tularémie – 10 bakterií
- Botulotoxin – 1–2 μg
- Giardióza – < 10 cyst
- Kryptosporidióza – 30 kokcidií
- Břišní tyf – nejméně 103
- Ostatní salmonelózy 105–109
- Cholera – 105–108
U většiny ale nelze stanovit přesné hraniční hodnoty. Další vývoj vztahu patogen – hostitel závisí i na dalších faktorech a vzniklých interakcích mezi nimi. Mikroorganismus musí být schopen se nejprve zachytit na těle nebo v těle svého hostitele. Aby byl úspěšný, musí být schopen se i v jeho těle šířit a množit. Hlavně v těchto fázích infekce se setkává s reakcí imunitního systému a musí překonávat jak přirozenou imunitu člověka, tak i jeho možnou lokální reakci. Dalším důležitým krokem je schopnost namnožení se v takovém kvantu, aby byl schopen po šíření z těla hostitele infikovat další jedince. Právě pro patogenní (parazitující) agens je typické obrovské množství namnožených jedinců nebo vývojových stádií, protože příroda kalkuluje s jejich velkými ztrátami při pobytu v „nepřátelském vnějším prostředí“ a se značnými ztrátami v boji s imunitním systémem nového hostitele. Úspěšných je jen velmi málo z obrovského počtu nově vzniklých jedinců. Ani v těchto fázích infekce nemusí nutně docházet k poškození hostitelského makroorganismu.
2.1.2
Možnosti přenosu nákaz
2.1.2.1
Přímý přenos
Přímý přenos znamená přenos přímo ze zdroje na vnímavého hostitele. Nutnou podmínkou je, že se tyto dva organismy musí setkat alespoň na krátký časový úsek, jehož délka se velmi nesnadno konkretizuje. V některých případech stačí několik málo okamžiků, jindy je nutný dlouhodobý kontakt. Možnosti tohoto přenosu jsou:
- přímým kontaktem se zdrojem (např. pohlavně přenosná onemocnění)
- přenos kontaminovanýma rukama
- infekčními kapénkami zpravidla na vzdálenost 1–2 metrů
- transplacentární přenos z matky na plod
- aspirace infekční plodové vody
- kontakt a manipulace s infikovaným zvířetem
- pokousáním nebo poškrábáním zvířetem
2.1.2.2
Nepřímý přenos
Zdroj nákazy již nemusí být přítomen v blízkosti nového hostitele a přenos nákazy může být zprostředkován:
+

Obr. 12. Potraviny jako možné vehikulum infekčních nemocí
+

Obr. 13. Komár jako možný vektor infekčních nemocí
Tyto dvě základní možnosti přenosu nákaz můžeme ještě rozšířit o přenos vertikální a horizontální. Jako vertikální přenos označujeme přenos z rodiče na potomka, horizontální přenos je šíření infekce z jednoho individua na ostatní jedince.
2.1.3
Charakteristika vnímavého jedince
O schopnosti infikovat se (onemocnět) rozhoduje celá řada faktorů a výsledný efekt této situace může být velmi rozmanitý. Rozeznáváme dvě krajní možnosti – absolutní vnímavost (jedinec se infikuje vždy) a absolutní odolnost (jedinec se nemůže infikovat).
Je nutno rozlišovat dvě skutečnosti:
- infekce organismu znamená vstup infekčního činitele do organismu
- onemocnění znamená projev klinických příznaků v různé intenzitě.
Ne vždy následkem infekce musí dojít k projevům onemocnění. U odolného makroorganismu většinou nedochází při expozici infekčními činiteli ani k jejich průniku do organismu. Dojde-li k němu, agens mohou projít organismem hostitele bez sebemenšího poškození zdraví. U vnímavých jedinců dochází při expozici ke vstupu do organismu vždy. Rozdílný je pouze následný projev infekce formou různě intenzivních klinických příznaků.
Odolnost i vnímavost k infekčním činitelům je dána druhovou příslušností (humánní infekce, onemocnění zvířat). V menší míře tuto schopnost ovlivňuje individualita jedince. Mezi individuální hlavní faktory ovlivňující vznik či průběh nákazy patří:
- věk jedince
- genetické dispozice
- momentální fyzická kondice
- psychický stav
- životní styl (sport, závislost na alkoholu, drogách, kuřáctví …)
- kvalita imunitního systému a schopnost jeho reakce
- očkovanost proti onemocněním
- možný současný výskyt jiného onemocnění a z toho plynoucí oslabení organismu
Není jednoduché stanovit žebříček důležitosti jednotlivých výše jmenovaných faktorů. Každý z nich má svůj význam a může celý proces zásadně kladně či záporně ovlivnit. Klíčovou roli hraje kvalita imunitního systému.
2.1.4
Vstupní brána infekce
Vstupní branou infekce rozumíme místo proniknutí původce onemocnění do těla hostitele. Tato schopnost je u různých původců odlišná. Patogenní mikroorganismy mají často velmi sofistikované mechanismy ve formě vlastních organel, biologických látek, které sami produkují, nebo schopnost manipulovat momentálním hostitelem (mezihostitelem) tak, aby se snáze šířily na další jedince. Opět jde v některých případech o umění překonat funkční obranné mechanismy imunitního systému.
Patogen tak může vniknout do hostitele:
- kůží (převážně porušenou poraněním nebo vektorem)
- sliznicí respiračního traktu
- sliznicí gastrointestinálního traktu
- sliznicí urogenitálního traktu
- oční spojivkou
2.1.5
Průběh infekčního onemocnění
Infekční onemocnění probíhá ve čtyřech stádiích, která na sebe plynule navazují.
- Inkubační doba
Začíná okamžikem vniknutí agens do organismu a trvá do objevení prvních příznaků nemoci. Je to čas nutný k pomnožení mikroorganismů, nebo k dokončení vývojových stádií mikrobů. Trvání od několika dnů po týdny až roky a pro každou nemoc je jiná a typická.
- Prodromální stadium
Je to období projevující se neurčitými příznaky, ze kterých ještě nelze stanovit diagnózu (zvýšená teplota, bolest hlavy a svalů, malátnost atd.). Trvá několik hodin, maximálně dny.
- Klinická manifestace
V této fázi se objevují charakteristické příznaky nemoci, jsou přítomny laboratorní známky příslušné infekce. Může probíhat akutně či chronicky.
- Rekonvalescence
Toto je fáze postupného uzdravování. Mizí příznaky nemoci, ale organismus je ještě oslaben.
2.1.6
Formy výskytu nákaz
V závislosti na čase a oblasti (nebo počtu osob), kde se onemocnění vyskytují, rozlišujeme několik forem výskytu onemocnění:
- Sporadický výskyt – výskyt pouze ojedinělých případů onemocnění bez zjevných epidemiologických souvislostí.
- Endemický výskyt – k opakovanému výskytu onemocnění dochází v určité ohraničené geografické oblasti.
- Epidemický výskyt – zvýšený výskyt určité konkrétní nemoci nad očekávané hodnoty. Překročí-li výskyt epidemie hranice více států nebo kontinentů, nazýváme toto pandemií.